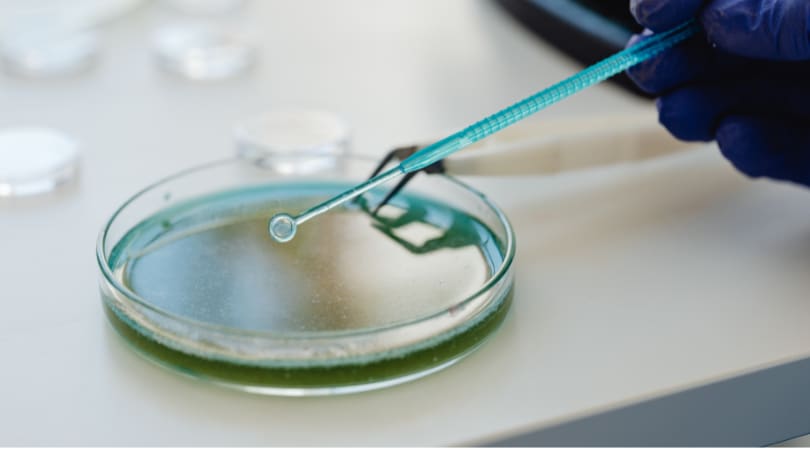

MLO Meewerkstage Microbiologie
- Op locatie
- Woerden, Utrecht, Nederland
- Normec Foodcare
Een ideale stage voor nieuwsgierige studenten die graag praktijkervaring willen opdoen in de microbiologie binnen de voedingsmiddelenindustrie.
Functieomschrijving
Duik in de wereld van microbiologie en werk mee aan de veiligheid van ons dagelijks voedsel. Tijdens deze MLO-stage krijg je de kans om jouw kennis direct toe te passen in een professioneel laboratorium, waar je werkt met voedingsmiddelen en moderne analysetechnieken. Je draait volwaardig mee in het team, ontwikkelt praktische vaardigheden en ontdekt hoe jouw werk bijdraagt aan kwaliteit en voedselveiligheid.
Jouw rol
Tijdens jouw stage draai je volledig mee in ons microbiologisch laboratorium. Je leert hoe we dagelijks de kwaliteit en veiligheid van diverse voedingsmiddelen controleren. Denk bijvoorbeeld aan chocola, kaas, vlees en vis. Uiteraard is er ook ruimte om te werken aan jouw schoolopdracht.
Je gaat onder andere:
Microbiologische analyses uitvoeren zoals:
Kiemgetalbepalingen
Detectie van pathogenen (Salmonella, Listeria, E. coli, Staphylococcus aureus)
Gist- en schimmelanalyses
Werken met moderne technieken zoals PCR
Resultaten verwerken in ons LIMS-systeem
Ons aanbod
Een leerzame en praktijkgerichte stage in een modern microbiologisch laboratorium
Werken in een gezellig en betrokken team
Begeleiding door ervaren laboratoriumspecialisten
Een stagevergoeding van € 300 bruto per maand
Een werkplek in Woerden, goed bereikbaar met het openbaar vervoer
Een stageperiode vanaf 4 maanden (startdatum in overleg)
Jouw profiel
Je volgt een MLO opleiding
Je hebt interesse in voedselveiligheid
Je werkt nauwkeurig en bent leergierig
Jouw nieuwe werkplek
Normec Foodlab ondersteunt de voedingsmiddelenindustrie met betrouwbare analyses op het gebied van voedselveiligheid en kwaliteit. Denk aan microbiologische testen op pathogenen, allergenen en chemische samenstelling.
Alle analyses worden uitgevoerd volgens strikte ISO 17025-normen.
Werken bij Normec Foodlab betekent ervaring opdoen in een professionele en innovatieve laboratoriumomgeving, waar kwaliteit, samenwerking en ontwikkeling centraal staan.
Over Normec
Normec Foodcare maakt deel uit van Normec, een vertrouwde leider in de Testing, Inspection, Certification en Compliance (TICC)-industrie. Onze expertise bestrijkt cruciale gebieden zoals water-, lucht- en bodemkwaliteit, brand- en voedselveiligheid, waarbij we de hoogste normen voor kwaliteit en veiligheid in diverse sectoren waarborgen. Normec is opgericht in 2016 en is een ambitieuze, onafhankelijke en snelgroeiende organisatie met ongeveer 6.500 duizend collega’s.
Wij bieden onze collega’s de mogelijkheid om bij te dragen aan onze missie en tegelijkertijd hun carrière te ontwikkelen in een dynamische, snel veranderende omgeving. Samen creëren we oplossingen die impact hebben voor onze klanten en bijdragen aan een duurzame toekomst. De kern van de Normec-cultuur, informeel, open, dynamisch en ambitieus ondernemend, is verankerd in onze GROWTH-principes. Dit brengen we tot leven met ons The Normec Fit-programma, dat ervoor zorgt dat niet alleen ons bedrijf groeit, maar ook iedereen die er deel van uitmaakt.
Interesse? Laten we kennismaken!
Ben je geïnteresseerd in deze stageplek? Dan kijken we uit naar jouw sollicitatie! We behandelen jouw gegevens vertrouwelijk en zorgen ervoor dat je binnen vijf werkdagen een reactie van ons ontvangt. Voor vragen over deze vacature kun je contact opnemen met Ellis Hulshorst, teamleider bij bij Normec Foodcare, via 06 23625502. Zij helpt je graag verder!
De procedure:
Eerste telefonische screening en verdere bespreking van de stageplek
Uitnodiging voor een gesprek waarna we samen bekijken of de stageopdracht bij je past
Gefeliciteerd, je hebt je nieuwe uitdaging gevonden
Op zoek naar een nieuwe uitdaging binnen de voedingsmiddelenindustrie, maar is deze functie niet helemaal wat je zoekt? Volg Careers at Normec Foodcare op LinkedIn en blijf op de hoogte van al onze vacatures.
Ongevraagde acquisitie door bureaus wordt niet op prijs gesteld en zal niet worden beantwoord.
of
Helemaal klaar!
Je sollicitatie is succesvol ingediend!
Je hebt al gesolliciteerd op deze vacature
We waarderen uw interesse in deze functie. Helaas heb je al gesolliciteerd op deze functie.
